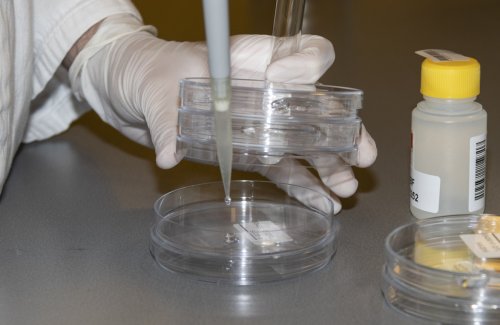
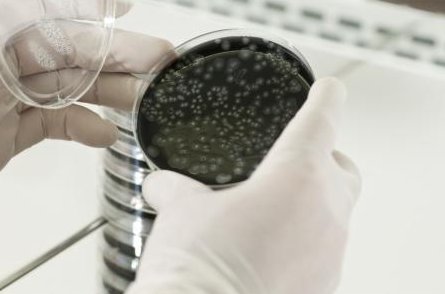

Geaccrediteerde watertesten
Als praktijkhouder is het welzijn van uw patiënten en medewerkers natuurlijk belangrijk voor je. Vervuild water zorgt voor slijtage van jouw apparatuur. Maar, wist je dat vervuild water gevaarlijk kan zijn voor jouw patiënten en mondzorgkundig team? Uit de praktijk blijkt dat maar liefst 70% van de behandelunits niet voldoen aan de gestelde norm van 100 KVE/ml. Wij helpen je graag bij het in kaart brengen van de kwaliteit van jouw unitwater. Met een microbiologische wateranalyse toetsen we of er in jouw installatie, bijvoorbeeld de dental unit of losstaand tandsteenapparatuur, bacteriën groeien die de waterkwaliteit in gevaar brengen.